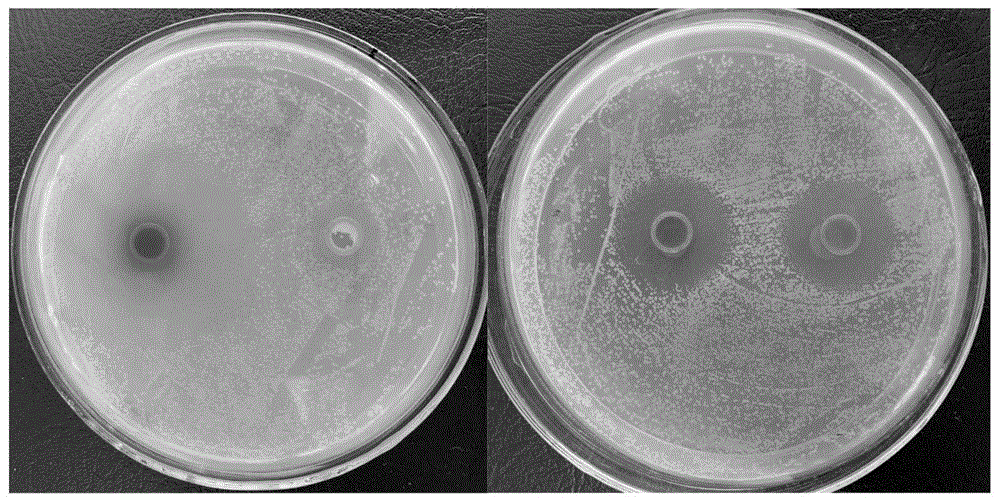
cn112358366a_用于防治梨火疫病的复合菌肥及其制备方法与应用在审

梨火疫病菌

梨火疫病
图片尺寸900x802
动植物检疫梨火疫病菌知多少
图片尺寸537x370
p>亚洲梨火疫病是由亚洲梨火疫病菌引起的,发生在 a target="_blank"
图片尺寸483x322
梨火疫病
图片尺寸1000x750
动植物检疫梨火疫病菌知多少
图片尺寸539x363
梨树火疫病
图片尺寸261x198
种植梨如何防治梨叶疫病
图片尺寸620x454
一种拮抗梨火疫病原菌的复合菌剂及其制备方法与应用
图片尺寸1000x506
cn112358366a_用于防治梨火疫病的复合菌肥及其制备方法与应用在审
图片尺寸1000x502
梨树:梨叶疫病
图片尺寸318x238
我国主要梨产区梨腐烂病菌培养表型与致病力差异的研究
图片尺寸774x498
发现家里种植的梨树得了火疫病怎么治
图片尺寸490x327
p>亚洲梨火疫病是由亚洲梨火疫病菌引起的,发生在 a target="_blank"
图片尺寸690x444
动植物检疫梨火疫病菌知多少
图片尺寸1080x810
种植梨如何防治梨火疫病?
图片尺寸620x493
(4)在梨树上的应用:梨黑星病,叶炭疽病,火疫病在开花前和落花后各喷1
图片尺寸600x473
一种防治梨火疫病菌引发病害的果树授粉方法
图片尺寸433x444
一株克雷伯氏菌及其在果树梨火疫病防治中的应用的制作方法
图片尺寸304x297
动植物检疫梨火疫病菌知多少
图片尺寸301x400
植株受火疫病菌侵害后,叶,嫩梢和果实等很快变黑枯萎,但病叶病果不
图片尺寸800x533